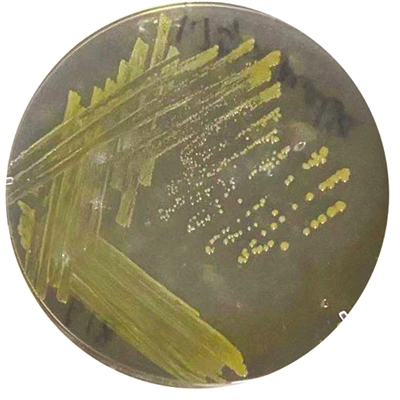

沉积物海微生态室菌

沉积物海微生态室菌

大鹏岛海杆菌
海岸带是陆域和海域生态系统的交界面,是集陆域和海域生态要素为一体的空间地带,生态环境非常敏感和脆弱,与社会经济发展和人居生活关联性强,是践行高质量发展的重要载体。
《中共中央 国务院关于支持深圳建设中国特色社会主义先行示范区的意见》提出“坚持生态优先,加强陆海统筹,严守生态红线,保护自然岸线。”《“十四五”全国海洋生态环境保护规划》设定了海洋环境质量改善、海洋生态保护修复两大类目标。《深圳市生态环境保护“十四五”规划》提出,“打造美丽海湾示范引领”,“加强海湾生态环境保护,着力保障海湾生态安全,提高生态风险预防和抵御能力。”《深圳率先打造美丽中国典范行动方案(2020年~2035年)》提出“建设美丽海湾城市”“提升亲海空间服务品质及公众亲海获得感,传承发扬海洋文化。到2025年,大鹏湾率先建成‘水清滩净、鱼鸥翔集、人海和谐’的美丽海湾”的重要目标。
广东省深圳市大鹏新区是国家生态文明建设示范区、国家生态文明先行示范区、国家级海洋生态文明建设示范区、国家级海洋牧场示范区和“绿水青山就是金山银山”实践创新基地,在全国“美丽海湾”建设中走在前列。在建设全球海洋中心城市集中承载区和世界级滨海生态旅游度假区的大背景下,大鹏新区针对海岸带单元组织开展了空间全覆盖、生态环境全要素评估与系统化监管体制机制研究,推动实现不同要素间互动关系从无到有、从有到优的建立,相关成果可为率先构建海岸带特色的现代环境治理体系提供重要支撑。
要素融合,率先开展陆海统筹多要素综合评估
长期以来,海岸带区域生态环境监管对象主要集中于水质、植被及海洋渔获物等方面,对海洋垃圾、沙滩、珊瑚等要素的关联性研究不足。大鹏新区率先以海岸带空间为评估主体,打破生态系统管理的单要素界限,针对典型生态空间、重点环境指标、社会经济发展指标、环境风险因子等四大类和海陆域17项生态环境要素及超过200个监测点位开展全年12批次月度调查监测,并进行综合分析评估,为大鹏新区率先构建海岸带特色的现代环境治理体系提供重要数据支撑。
特色鲜明,首次开展海岸带微生物监测评估
大鹏新区针对海洋环境保护存在的主要问题,重点开展了海漂垃圾、海岸带微生物监测评估工作。一是参考国内外标准,首次对大鹏新区近岸海域海漂垃圾开展空间和时间全覆盖的月度监测,并分析其数量、种类及来源,探讨海滩垃圾和海漂垃圾分布特征及存在问题,为海岸带垃圾监测及管理提供基础数据支撑及决策依据。二是基于微生物宏组学的方法,首次利用宏基因组、宏病毒组方法对海岸的潮滩区和滨海区进行了微生物多样性的摸底调查,从毒力因子、病原与宿主、抗生素基因以及致病基因四个方面对环境中潜在的微生物安全问题进行了初步评估,利用实验室培养的方法对大鹏新区海岸带的可培养性细菌资源进行了分离与鉴定,并在结论的基础上提出相应的对策建议。
分类分级,探索海岸带生态环境要素管理
大鹏新区生态环境要素多样且差异较大,综合采用定性研究与定量研究相结合的方法,以增强生态环境监管能力为目标,开展单要素时空序列、不同要素间的量化关系研究,构建量化分类及定性评级分析体系,进而探索分类分级的海岸带生态环境要素管理措施。如针对岸线,分为严格保护(红树林分布区、河口、大部分基岩岸线等)、限制开发(具有景观功能的砂质岸线)、优化利用(码头、海堤等)三个类别进行管理;针对沙滩,可分为旅游型沙滩(较场尾、金沙湾、玫瑰海岸、东涌、西涌、桔钓沙等)、渔业型沙滩(下企沙滩、望鱼角沙滩等)、自然保育型沙滩(大鹿湾沙滩、山海湾沙滩等)、急需修复型沙滩(大水坑沙滩等)等类别进行管理。
复合视角,系统谋划海岸带环境治理措施
海岸带区域既是生态环境敏感区,也是重要的生产活动区。大鹏新区从“生态—社会—经济”复合视角出发,重点对坝光片区、新大片区、金沙湾片区等承担着重要社会经济生产活动功能的海湾,系统谋划海岸带生态环境治理措施。如坝光片区,在开发建设的规划、实施各阶段均以生态环境优先为基本原则,高规格布置生态廊道,开展岸线保护修复,提升河流水环境。同时,在系统掌握坝光片区天然古银叶树群落结构及物种分布基础上,开展生态系统健康度评估,为持续开展红树林保护修复提供量化指引。又如金沙湾片区,在海水质量、沙滩质量、海域海岛利用、珊瑚分布区等综合分析评估基础上,提出了片区联动的综合治理模式,推动生态景观、生态安全、生态文化同步提高,在优质旅游产品开发过程中提高海湾生态质量,形成良性互动。
统筹成果,全力推进高品质美丽海湾建设
海岸带生态环境综合调查的成果,为大鹏新区全力推进高品质美丽海湾建设,打造全球海洋中心城市集中承载区提供了科学支撑。一是实现对大鹏新区海岸带区域空间统筹的生态环境多要素、社会经济状况多维度数据资料收集、调查和监测,明确了大鹏新区海岸带区域现状条件;二是对大鹏新区海岸带区域不同管理单元生态环境质量进行单项和综合评价;开展关键生态影响研究,统筹开展了大鹏新区海岸带生产空间、生活空间和生态空间综合分析;通过分析评价,明确了大鹏新区海岸线上不同空间单元的关键影响因子及制约要素;三是以增强大鹏新区海岸带区域生态功能与环境质量为导向,开展大鹏新区海岸带区域生态环境治理对策研究,实现对大鹏新区海岸带区域这一重要生态屏障和发展聚集区的系统化管理。开展海岸带生态环境综合调查工作是“绿水青山就是金山银山”理念在大鹏新区海湾治理中的践行之举,调查工作明确以各项生态环境要素和社会经济要素为核心建立了大鹏新区海岸带要素间互动关系,建立了不同要素间的影响条件及作用机制,从而拓展了大鹏新区生态环境监管触角,增强了区域生态环境监管覆盖度,完善生态环境监管联动模式,为“美丽海湾”建设提供了具体支撑和保障,具有重要的应用示范意义。
创新利用,以生态资源助推社会经济高质量发展
深圳市生态环境局大鹏管理局在开展海岸带生态资源调查评估工作中,率先发现并命名两株新的海洋菌种资源—大鹏岛海杆菌和沉积物海微生态室菌,为精细化开展海洋生物资源保护提供示范,具有重要的生物产品开发应用价值。
大鹏岛海杆菌(Maritimibacter dapengensis)是从大鹏半岛东部海域发现的可用于合成可降解高分子材料的革兰氏阴性菌,从杨梅坑珊瑚区的底泥中分离得到。研究团队利用系统发育、生理和生化鉴定,确定这种菌为海杆菌属的新物种,并以发现地大鹏半岛命名。这种菌成为国际上首株以大鹏半岛命名的微生物物种,对于率先开展海洋微生物资源保护与开发具有重要应用示范效用,从精细化视角推动高品质生态文明建设。
沉积物海微生态室菌(Mameliella sediminis)是从大鹏半岛以东的大亚湾海域采集获得,提取于王母河入海口沉积物中。研究团队基于细菌鉴定多相分类法,从系统发育、生理和生化三个方面全面鉴定了这种菌的特征,确定这种菌为海微生态室菌属的新物种,因为这种菌来自大鹏半岛近岸海域沉积物样品,故将其命名为“沉积物海微生态室菌”,成为受到国际认可的微生物新物种。同时,这种菌具有重要的生物材料研发和规模化生产潜力,可成为海洋生态产业化的重要示范案例。
海洋里除了常见的25万种海洋动植物,还分布着2亿~10亿种微生物。丰富的海洋微生物及其在代谢、生理、遗传进化等方面的多样性,是海洋源生物材料的重要生产力之一。大鹏岛发现并命名的两株海洋微生物资源,已验证的具有产品开发优势,在下游生物材料开发联动基础上,将与大鹏半岛生物谷建设形成高效联动。
海洋来源的生物材料,如甲壳质、褐藻胶、胶原蛋白等,没有携带哺乳动物的疾病和传染病的风险,具有良好的生物相容性、可降解性、生物活性和加工性能,可作为组织工程产品支架材料、伤口敷料及药物载体材料使用。随着科技的发展与进步,海洋生物材料的开发与应用市场前景日益广阔,也越来越受到世界各国政府和研究开发机构的重视。目前,在研究论文中报道的海洋生物医用材料主要为多糖和蛋白质,多糖包括甲壳素、壳聚糖、寡聚糖、海藻酸盐和透明质酸钠,蛋白质主要为胶原蛋白。这些材料主要来源于鱼、虾、蟹等海洋动物的皮、骨、外壳等以及海藻类海洋植物细胞。对于海洋微生物来源的生物材料,却少有研究报道。大鹏新区将围绕党工委会确定的“一二三四”发展战略,着力打造全球海洋中心城市集中承载区和世界级滨海生态旅游度假区,继续大力推动海洋微生物资源开发及应用,全面深化生态产业化、产业生态化的经济体系建设。 (林琳)